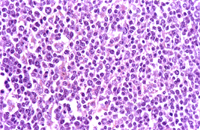
圖4：在高倍下可見腫瘤細胞藍染或淡染，細胞大小不一外型由卵圓型到多邊型，核質比高，質呈淡藍，偶爾可見有絲分裂相。

豬 淋 巴 肉 瘤
- 英文名稱
- Lymphosarcoma in Pig
- 作者
- 游志煌
- 建立日期
- 96年01月22日
- 更新日期
- 96年01月22日
- 內容
一 、
病 歷:
本病例由宜蘭縣衛生局提供,此組織來自屠體衛生檢查時發現,該病例屠前檢查可見豬隻皮膚較蒼白外無其他臨床症狀。
二 、
肉眼病變:
肝臟:
輕度偏黃色且硬實,於漿膜面可見直徑約0.5 ~ 1cm白色大小不一之斑點,其白色之病變隨著肝小葉間質延伸而形成斑紋狀(圖2) 。

脾臟:
輕度腫脹,漿膜面可見直徑約0.1 ~ 1cm大小之乳白色結節。 腎臟:
皮質表面密發點狀至直徑約0.1 ~ 1cm大小之圓型病變,讓圓型病變輕微突出,外圍為紅色,其中心部呈淡紅色(圖 1),於福馬林固定後此圓型病變之突出更明顯,讓病變散發於皮質各區域但未深入髓質部。

三 、
組織病變:
腎臟:
腎臟間質可見多發腫瘤細胞浸潤,病灶周圍可見出血帶(圖3),大面積的腫瘤區內可見少數殘存的腎小管或絲球體。在高倍下可見腫瘤細胞藍染或淡染,細胞大小不一外型由卵圓型到多邊型,核質比高,質呈淡藍,偶爾可見有絲分裂(圖 4)。
肝臟: 肝可見較廣泛的腫瘤細胞浸潤,此腫瘤細胞隨著肝小葉間質生長,且逐漸伸入正常的肝小葉內使整個腫瘤細胞呈網狀結構,但在大區域病灶區其肝細胞有的已完全消失或於病灶區內僅殘存少數正常的肝細胞如小島樣。在未形成腫瘤的正常肝小葉之肝竇隙內亦見少量的腫瘤細胞浸潤。肝之腫瘤細胞型態與腎相同。 脾臟: 紅、白髓之淋巴球屬正常之型態,惟自肉眼病變突出結節部亦見上述肝臟及腎臟之腫瘤細胞。 四、
診 斷: 豬淋巴肉瘤(Lymphosarcoma in Pig)。 五、
討論: 此病例肝呈微黃色及白色斑紋一般均認為可能是脂肪肝或蝸蟲斑,而腎臟之病變誤為出血斑點,脾臟之結節常以化膿灶而予以判定廢棄,由此可知屠體檢查之病材結合病理切片檢驗實屬必要。